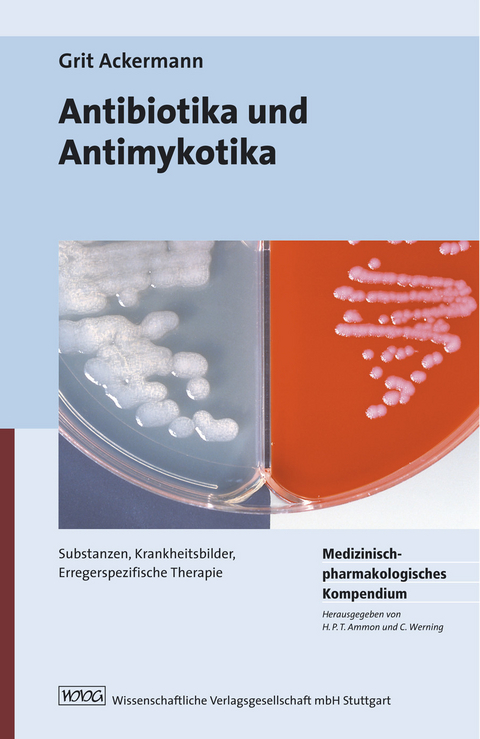
Antibiotika und Antimykotika -

Antibiotika und Antimykotika (eBook)
XXIV, 585 Seiten
Wissenschaftliche Verlagsgesellschaft Stuttgart
978-3-8047-2620-8 (ISBN)
Der richtige Einsatz eines Antibiotikums erfordert Fachwissen und Fingerspitzengefühl, denn die Therapie sollte effektiv, kostengünstig und für den Patienten gut verträglich sein.
Ein Spezialistenteam hat in dieser komplett neu verfassten 3. Auflage alle Fakten zu Antibiotika und Antimykotika sowie Antituberkulotika für Sie zusammengestellt:
• Daten zur Pharmakokinetik und Dosierungen sämtlicher Wirkstoffe, auch für Patienten mit Nierenfunktionsstörungen,
• Therapieregimes bei verschiedenen Infektionskrankheiten,
• Wirkungsspektren und Resistenzprofile.
Das Werk eignet sich aufgrund seiner klaren Einteilung somit hervorragend für das Nachschlagen bei Fragestellungen
• zur Wirkstoffklasse und Substanzen,
• zu einzelnen Erregern sowie
• zur Behandlung von Krankheitsbildern.
Ausführliche Literaturangaben geben Transparenz und Sicherheit. Zeigen Sie Ihre Kompetenz durch Fachwissen!
front.pdf 1
9783804726208 2
back 585
| Erscheint lt. Verlag | 28.5.2010 |
|---|---|
| Zusatzinfo | 293 schw.-w. Tab., 27 schw.-w. Zeichn. |
| Sprache | deutsch |
| Themenwelt | Medizin / Pharmazie ► Pharmazie |
| ISBN-10 | 3-8047-2620-8 / 3804726208 |
| ISBN-13 | 978-3-8047-2620-8 / 9783804726208 |
| Informationen gemäß Produktsicherheitsverordnung (GPSR) | |
| Haben Sie eine Frage zum Produkt? |
Größe: 5,2 MB
DRM: Digitales Wasserzeichen
Dieses eBook enthält ein digitales Wasserzeichen und ist damit für Sie personalisiert. Bei einer missbräuchlichen Weitergabe des eBooks an Dritte ist eine Rückverfolgung an die Quelle möglich.
Dateiformat: PDF (Portable Document Format)
Mit einem festen Seitenlayout eignet sich die PDF besonders für Fachbücher mit Spalten, Tabellen und Abbildungen. Eine PDF kann auf fast allen Geräten angezeigt werden, ist aber für kleine Displays (Smartphone, eReader) nur eingeschränkt geeignet.
Systemvoraussetzungen:
PC/Mac: Mit einem PC oder Mac können Sie dieses eBook lesen. Sie benötigen dafür einen PDF-Viewer - z.B. den Adobe Reader oder Adobe Digital Editions.
eReader: Dieses eBook kann mit (fast) allen eBook-Readern gelesen werden. Mit dem amazon-Kindle ist es aber nicht kompatibel.
Smartphone/Tablet: Egal ob Apple oder Android, dieses eBook können Sie lesen. Sie benötigen dafür einen PDF-Viewer - z.B. die kostenlose Adobe Digital Editions-App.
Zusätzliches Feature: Online Lesen
Dieses eBook können Sie zusätzlich zum Download auch online im Webbrowser lesen.
Buying eBooks from abroad
For tax law reasons we can sell eBooks just within Germany and Switzerland. Regrettably we cannot fulfill eBook-orders from other countries.
aus dem Bereich


